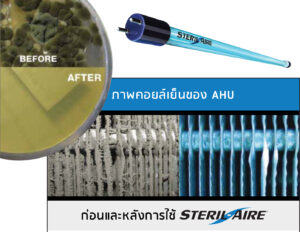

STERIL – AIRE
ระบบการใช้รังสีอัลตราไวโอเลตซีเพื่อการฆ่าเชื้อ สำหรับติดตั้งหน้าคอยล์เย็นของ AHU ในระบบปรับอากาศ
- Details
- Company Info
Details
Brand : STERIL -AIRE
Model : STERIL -AIRE
STERIL -AIRE (สเตอริล-แอร์) ผลิตภัณฑ์จากสหรัฐอเมริกา เป็นระบบ Germicdal UVC หรือ UVGI หรือยูวีซีเพื่อการฆ่าเชื้อ สำหรับติดตั้งหน้าคอยล์เย็นของ AHU ในระบบปรับอากาศ โดยระบบยูวีซีจะช่วยทำความสะอาดคอยล์เย็นด้วยการขจัดไบโอฟิล์มบนครีบคอยล์ ทำให้การทำงานของคอยล์เย็นดีขึ้น ช่วยประหยัดพลังงานและขจัดเชื้อโรค ปรับปรุงคุณภาพอากาศภายในอาคารให้ดีขึ้น ระบบยูวีซีของ STERIL -AIRE นี้เป็นอุปกรณ์ครบชุด สามารถเลือกใช้ตามขนาดพื้นที่หน้าตัดของคอยล์เย็น โดยใช้ซอฟต์แวร์ในการคำนวณหลอดที่ต้องใช้เพื่อให้ได้ประสิทธิภาพสูงสุด
Company Info

LEAFPOWER CO., LTD.
We are importer and distributor of clean air and safety products for thai market.
More Company Detail